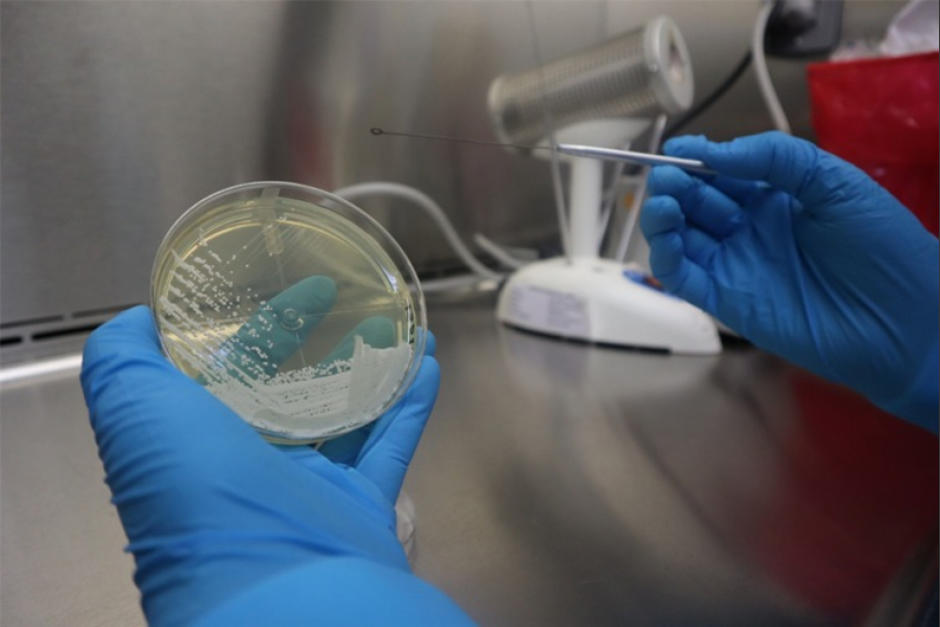
El Ministerio de Salud señaló que no han detectado más casos. (Foto: Ministerio de Salud)

El Ministerio de Salud emitió una alerta epidemiológica por el primer hallazgo del hongo Candida Auris en Guatemala.
TAMBIÉN: Emergencia en Guatemala por plaga de langostas voladoras
Este hongo puede provocar infecciones profundas en órganos y tejidos de personas con el sistema inmunológico debilitado y es considerado peligroso debido a que es altamente resistente a los medicamentos.
"Candida Auris es una levadura u hongo emergente, es decir que es considerado como un hallazgo nuevo en su especie", señala la cartera salubrista en su página de internet.
En diciembre de 2020, un hombre de 32 años llegó al Hospital Roosevelt con una infección en la tibia derecha. El Laboratorio Nacional de Salud lo evaluó y confirmó que tenía este hongo.
El paciente reportó que no había viajado recientemente y permaneció aislado. A finales de enero, el Ministerio de Salud le dio notificó a los laboratorios, hospitales públicos y privados y áreas de Salud acerca del hallazgo.
El Ministerio de Salud enfatiza en que los contagios por Candida Auris se dan principalmente en los hospitales. No obstante, asegura que de momento no se han detectado más casos en el país.
- MIRA AQUÍ: